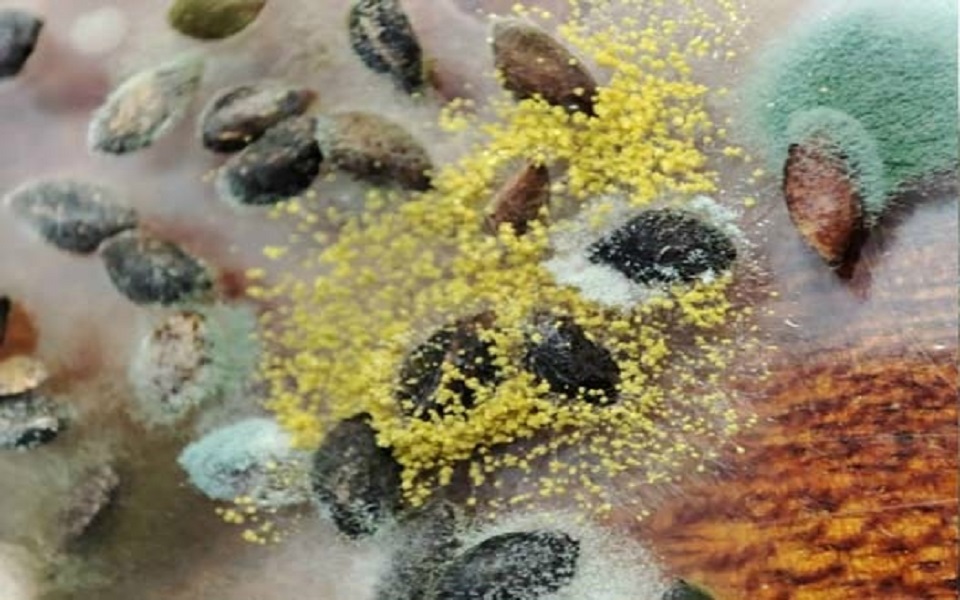

Половина материала непригодна для длительного хранения.
Специалисты Центра защиты леса Рязанской области оценили качество пяти партий семян сосны обыкновенной общим весом в 121 кг.
4% семян оказались заражены паразитными грибами рода Альтернария, которые снижают их качество при хранении, а в последствии могут привести к загниванию проростков и полеганию всходов.
При проверке также были выявлены сапрофитные грибы, из-за которых семена при хранении портятся и потом плохо всходят.
В итоге семена были разделены на две партии. Одна – третьего класса качества (61 кг). Эти семена нельзя хранить и необходимо высадить в ближайший сезон. Вторая – первого класса (60 кг). Их можно хранить.
Больше новостей в нашем и в группе . Подписывайтесь - и будьте в курсе главных событий.